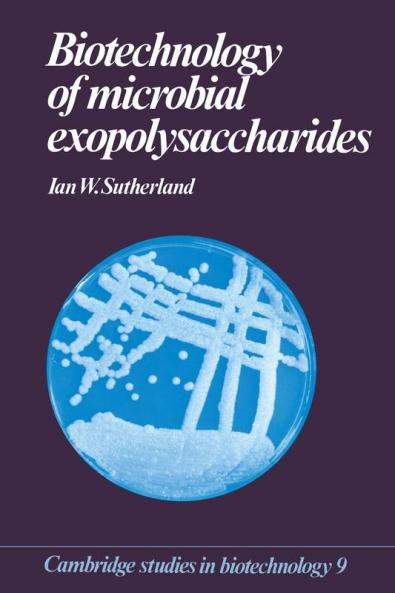
Biotechnology of Microbial Exopolysaccharides

English
Hardback
₹12156
(All inclusive*)
Delivery Options
Please enter pincode to check delivery time.
*COD & Shipping Charges may apply on certain items.
Review final details at checkout.
Looking to place a bulk order? SUBMIT DETAILS
Delivery Options
Please enter pincode to check delivery time.
*COD & Shipping Charges may apply on certain items.
Review final details at checkout.
About The Book
Description
Author(s)
This volume provides a thorough account of the structure and synthesis of microbial exopolysaccharides and of their widespread application across a broad range of industries including food oil and medicine. The successful exploitation of these polysaccharides requires a sound scientific understanding of their chemical and physical properties and also their biochemistry and biosynthesis.
Details
ISBN 13
9780521363501
Publication Date
-18-10-1990
Pages
-172
Weight
-330 grams
Dimensions
-152.4x228.6x11.22 mm